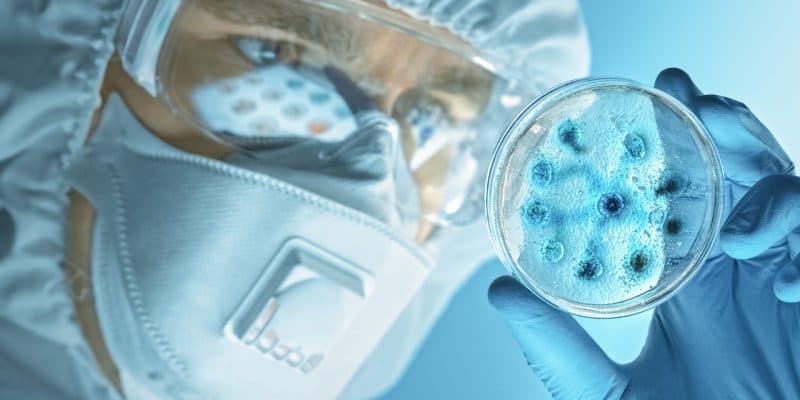
Covid 19 liek domāt kritiski

Uztura bagātinātāji: kā gudri iekļaut savā rutīnā
Neliels, bet nozīmīgs ieradums, kas palīdz uzturēt veselību, enerģiju un labu pašsajūtu ilgtermiņā.
Jānis Blūms: “Labāk mazāk – bet ar galvu!”
Ja tev būs daudz darba, bet nebūs veselības – nu, kam tu īsti esi vajadzīgs? Tāpēc labāk mēģināt abus savienot – darbus un rūpes par ķermeni.
Lotos Pharma vadītājs: “Jāaug tur, kur esi piedzimis!“
Latvijas farmācijas uzņēmums “Lotos Pharma”, dibināts 2013. gadā, izceļas ar straujo izaugsmi, augstākajiem standartiem atbilstošu ražošanu un produktiem.
Anatolijs Kreipāns: “Lieli savainojumi bieži vien sākas no maziem”
Ja nebūtu mūsdienu sporta medicīnas farmakoloģijas, būtu daudz, daudz un vēlreiz daudz sliktāk sportistiem ar veselību.
Roberto Meloni: “Tas esi tu pats, kas izvēlies”
Tā mācība bija ļoti mokoša, un es ļoti daudz iemācījos. Un es nedaudz vainoju sevi…
Vīruss: aktuālās prognozes sezonai
Šņaukāties un klepot – nu nē! Tagad nevienam nav vēlmes slimot un iegūt “vārguļa” imidžu.
Locītavu slimību novēršanā svarīga ir vingrošana un uzturvielas
Locītavas ir nozīmīgi balsta un kustību sistēmas elementi un dod iespēju pārvietoties. Visā pasaulē dramatiski pieaug to cilvēku skaits, kuri sirgst ar dažādām locītavu slimībām, turklāt slimnieki kļūst gados aizvien jaunāki.
Slimojot ar gripu, cilvēks jau nenomirst no tā, ka viņam sāp kakls
Jaunākais par to, kā sadzīvot ar vīrusiem, kādi ir populārākie mīti par gripu, Covid-19 un citām vīrusu saslimšanām, kā rīkoties, sajūtot pirmās slimības pazīmēs.
Mums ir jāmainās. Mentālās veselības sekas COVID laikā!
“Es nedomāju, ka būtu drudžaini jāgatavojas kādai apokalipsei, bet vienkārši jābūt gataviem pārmaiņām. Ja kovids pāries un dzīve būs vieglāka, tad ļoti jauki. Ārējie apstākļi būs vieglāki, bet mēs būsim kļuvuši spēcīgāki.” Saruna ar psihoterapeitu Artūru Miksonu.
Satiec savu farmaceitu
Šajā sarežģītajā pandēmijas laikā farmaceits dažbrīd izrādās gandrīz vienīgais veselības aprūpes speciālists, pie kā cilvēks var nokļūt uzreiz un bez šķēršļiem, aprunāties par savu vai tuvinieka veselību, meklēt palīdzību. Par farmaceita ikdienu un ieteikumiem Covid-19 sakarā stāsta farmaceite Madara Bērziņa.
“Garā kovida” noslēpumi
Par to, kas notiek ar organismu slimības laikā un kā smagās sekas atvieglot, saruna ar ģimenes ārsti Karīnu Verneri.
AteroLip® fiber – jaunums sirds un asinsvadu veselībai
AteroLip® fiber ir pirmais uzņēmuma ražotais produkts, kur precīzi dozēts pulveris ir iefasēts atsevišķās paciņās, kas sniedz iespēju nodrošināt lielāku vienas vienības devu. Lai šo realizētu, uzņēmums, investējot līdzekļus, ir papildinājis savu ražotni ar jaunām iekārtām.
Svarīgie spēlētāji imunitātes un vīrusu aizsardzības komandā
Uztvert savu organismu kā saliedētu komandu, lai neļautu pielavīties slimībai. Tas ir svarīgs uzdevums ikvienam no mums, īpaši šajā laikā. Svarīgs komandas balsts ir imunitāte. Kas tai kaitē un kā imunitāti stiprināt? Sarunā iesaka pieredzējusī ģimenes ārste Karīna Vernere.
Augsts holesterīns. Ko nu?
Kā no tā iespējams izvairīties no paaugstināta holesterīna un cukura līmeņa asinīs, kā par sevi parūpēties? Uz sarunu aicinām Veselības centru apvienības „Aura” un Latvijas Jūras medicīnas centra Sarkandaugavas ambulatorās veselības aprūpes centra endokrinoloģi, internisti Dr. Maiju Gureviču.
Covid-19 liek domāt kritiski
Sarunā ar Paula Stradiņa Klīniskās universitātes slimnīcas Nefroloģijas centra ārstu internistu Kārli Rāceni vēlējāmies noskaidrot, kā vislabāk cīnīties ar šobrīd galveno draudu sabiedrības veselībai un kā cilvēkam sevi labāk pasargāt no vīrusu infekcijām.
Iemācīties aizmigt
Kā iemācīties aizmigt, kad to vēlamies, un labi izgulēties? Lotos Pharma saruna ar Miega slimību centra speciālisti Dr. Natāliju Bērziņu.
Arī aknas baidās no Covid-19
Par aknām un to veselību saruna ar Rīgas Stradiņa universitātes Infektoloģijas katedras vadītāju, hepatoloģi, Latvijas Zinātņu akadēmijas korespondētājlocekli, dr.habil. med. profesori Ludmilu Vīksnu.
Good Fiber – jauns risinājums svara samazināšanai
Latvijas farmācijas uzņēmums Lotos Pharma ir izstrādājis jaunu produktu Good Fiber svara samazināšanai, kas paredzēts arī bērniem ar paaugstināta svara problēmām.
Intervija par locītavu veselību ar ORTO klīnikas traumatologu-ortopēdu Dr. Andreju Peredistiju
Akūtu vai hronisku slimību radītas locītavu sāpes ievērojami ietekmē cilvēka darbaspējas un dzīves kvalitāti. Kā tās mazināt, kā rūpēties par savu locītavu veselību – intervijā stāsta sertificēts ORTO klīnikas traumatologs-ortopēds Dr. Andrejs Peredistijs.
Ivars Kalviņš: «Ieklausieties zinātniekos!»
Par to, kā pasargāt sevi no saslimšanas un neapmaldīties informācijas džungļos, uz sarunu esam aicinājuši Zinātņu akadēmijas prezidentu, vienu no slavenā mildronāta izgudrotājiem akadēmiķi Ivaru Kalviņu.
Projekta Bio4ASIA ietvaros uzsāk produkta stabilitātes testus
Latvijas uzņēmums Lotos Pharma un Igaunijas uzņēmums BioCC OÜ projekta Bio4ASIA ietvaros kopīgi izstrādā jaunu inovatīvu un efektīvu
Lotos Pharma iegūst jaunu kvalitātes sertifikātu ISO 22000
Uzņēmums Lotos Pharma pirms nepilniem diviem gadiem atklāja jaunu ražotni Mārupē, kas atbilst labas ražošanas prakses standartiem. To